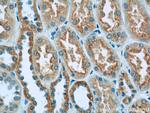
GFM1 Antibody in Immunohistochemistry (Paraffin) (IHC (P))

Search
Proteintech
GFM1 Polyclonal Antibody
{{$productOrderCtrl.translations['antibody.pdp.commerceCard.promotion.promotions']}}
{{$productOrderCtrl.translations['antibody.pdp.commerceCard.promotion.viewpromo']}}
{{$productOrderCtrl.translations['antibody.pdp.commerceCard.promotion.promocode']}}: {{promo.promoCode}} {{promo.promoTitle}} {{promo.promoDescription}}. {{$productOrderCtrl.translations['antibody.pdp.commerceCard.promotion.learnmore']}}

Please note: We are reviewing Western blot images included in the antibody testing data in our catalog, including those provided by third parties. Unless expressly labeled or annotated as “raw-unedited”, Western blot images included in the antibody testing data in our catalog may have been edited, optimized or otherwise adjusted for presentation.
产品信息
14274-1-AP
种属反应
已发表种属
宿主/亚型
分类
类型
抗原
偶联物
形式
浓度
规格
纯化类型
保存液
内含物
保存条件
运输条件
产品详细信息
Immunogen sequence: RMHADMMED VEEVYAGDIC ALFGIDCASG DTFTDKANSG LSMESIHVPD PVISIAMKPS NKNDLEKFSK GIGRFTREDP TFKVYFDTEN KETVISGMGE LHLEIYAQRL EREYGCPCIT GKPKVAFRET ITAPVPFDFT HKKQSGGAGQ YGKVIGVLEP LDPEDYTKLE FSDETFGSNI PKQFVPAVEK GFLDACEKGP LSGHKLSGLR FVLQDGAHHM VDSNEISFIR AGEGALKQAL ANATLCILEP IMAVEVVAPN EFQGQVIAGI NRRHGVITGQ DGVEDYFTLY ADVPLNDMFG YSTELRSCTE GKGEYTMEYS RYQPCLPSTQ EDVINKYLEA TGQLPVKKGK AKN (400-751 aa encoded by BC049210)
靶标信息
Eukaryotes contain two protein translational systems, one in the cytoplasm and one in the mitochondria. Mitochondrial translation is crucial for maintaining mitochondrial function and mutations in this system lead to a breakdown in the respiratory chain-oxidative phosphorylation system and to impaired maintenance of mitochondrial DNA. This gene encodes one of the mitochondrial translation elongation factors. Its role in the regulation of normal mitochondrial function and in different disease states attributed to mitochondrial dysfunction is not known.
仅用于科研。不用于诊断过程。未经明确授权不得转售。
生物信息学
蛋白别名: EF-Gmt; EF-Gmt {ECO:0000255|HAMAP-Rule:MF_03061}; Elongation factor G 1, mitochondrial; elongation factor G 1, mitochondrial {ECO:0000255|HAMAP-Rule:MF_03061}; Elongation factor G, mitochondrial; elongation factor G, mitochondrial {ECO:0000255|HAMAP-Rule:MF_03061}; Elongation factor G1; elongation factor G1 {ECO:0000255|HAMAP-Rule:MF_03061}; G elongation factor 1; mEF-G 1; mEF-G 1 {ECO:0000255|HAMAP-Rule:MF_03061}; mitochondrial; mitochondrial elongation factor G
基因别名: AW545374; D3Wsu133e; EF-G; Efg; Efg1; Gfm; Gfm1
UniProt ID: (Mouse) Q8K0D5, (Rat) Q07803
Entrez Gene ID: (Mouse) 28030, (Rat) 114017




